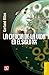
La ciencia de la vida en el...

George Basalla
More books by George Basalla…
Topics Mentioning This Author
| topics | posts | views | last activity | |
|---|---|---|---|---|
| Hooked on Books : Richard's 2024 Challenge Tracker | 361 | 145 | Jun 12, 2025 08:45AM | |
| Crazy Challenge C...: Old, Obsolete, and Obscure Words 1 - Insults | 91 | 60 | Oct 20, 2025 02:43PM | |
| Crazy Challenge C...: World's Strangest Festivals | 100 | 78 | Nov 24, 2025 11:43AM |
Is this you? Let us know. If not, help out and invite George to Goodreads.